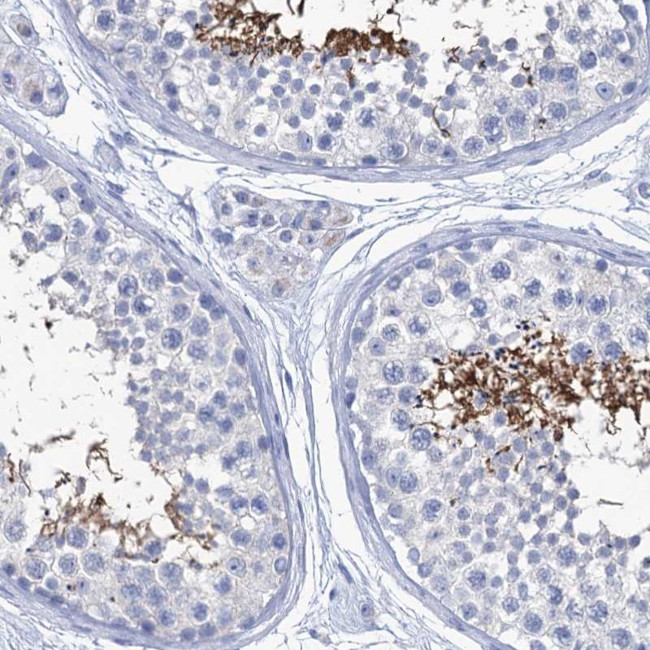
CABYR Antibody in Immunohistochemistry (Paraffin) (IHC (P))

Search
Invitrogen
CABYR Polyclonal Antibody
{{$productOrderCtrl.translations['antibody.pdp.commerceCard.promotion.promotions']}}
{{$productOrderCtrl.translations['antibody.pdp.commerceCard.promotion.viewpromo']}}
{{$productOrderCtrl.translations['antibody.pdp.commerceCard.promotion.promocode']}}: {{promo.promoCode}} {{promo.promoTitle}} {{promo.promoDescription}}. {{$productOrderCtrl.translations['antibody.pdp.commerceCard.promotion.learnmore']}}




Please note: We are reviewing Western blot images included in the antibody testing data in our catalog, including those provided by third parties. Unless expressly labeled or annotated as “raw-unedited”, Western blot images included in the antibody testing data in our catalog may have been edited, optimized or otherwise adjusted for presentation.
产品信息
PA5-59256
种属反应
宿主/亚型
分类
类型
抗原
偶联物
形式
浓度
规格
纯化类型
保存液
内含物
保存条件
运输条件
RRID
产品详细信息
Immunogen sequence: GKVSSIHSDQ SDVLMVDVAT SMPVVIKEVP SSEAAEDVMV AAPLVCSGKV LEVQVVNQTS VHVDLGSQPK ENEAEPSTAS SVPLQDEQEP PAY
Highest antigen sequence identity to the following orthologs: Mouse - 55%, Rat - 56%.
靶标信息
Spermatozoa gain fertilization capacitation and hyperactivation after residing in the uterus or oviduct. Calcium, cAMP and protein tyrosine phosphorylation are necessary for the molecular mechanisms that allow for this transformation. CABYR (Calcium-binding tyrosine phosphorylation-regulated protein), also known as Fibrousheathin-2 or Cancer/testis antigen 88, is a 493 amino acid protein that is expressed in sperm flagella and exhibits increased tyrosine phosphorylation during capacitation. There are six named isoforms of CABYR that are produced as a result of alternative slicing events. Specifically, isoform 1 is expressed in the testis, while isoform 3 and isoform 5 are expressed in pancreas, brain and various brain tumors. Isoforms 1, 2 and 6 most likely bind calcium, whereas isoforms 3, 4 and 5 probably do not bind calcium.
仅用于科研。不用于诊断过程。未经明确授权不得转售。
篇参考文献 (0)
生物信息学
蛋白别名: Calcium-binding protein 86; Calcium-binding tyrosine phosphorylation-regulated protein; Cancer/testis antigen 88; CT88; Fibrousheathin II; Fibrousheathin-2; FSP-2; Testis-specific calcium-binding protein CBP86
基因别名: CABYR; CBP86; FSP2
Entrez Gene ID: (Human) 26256